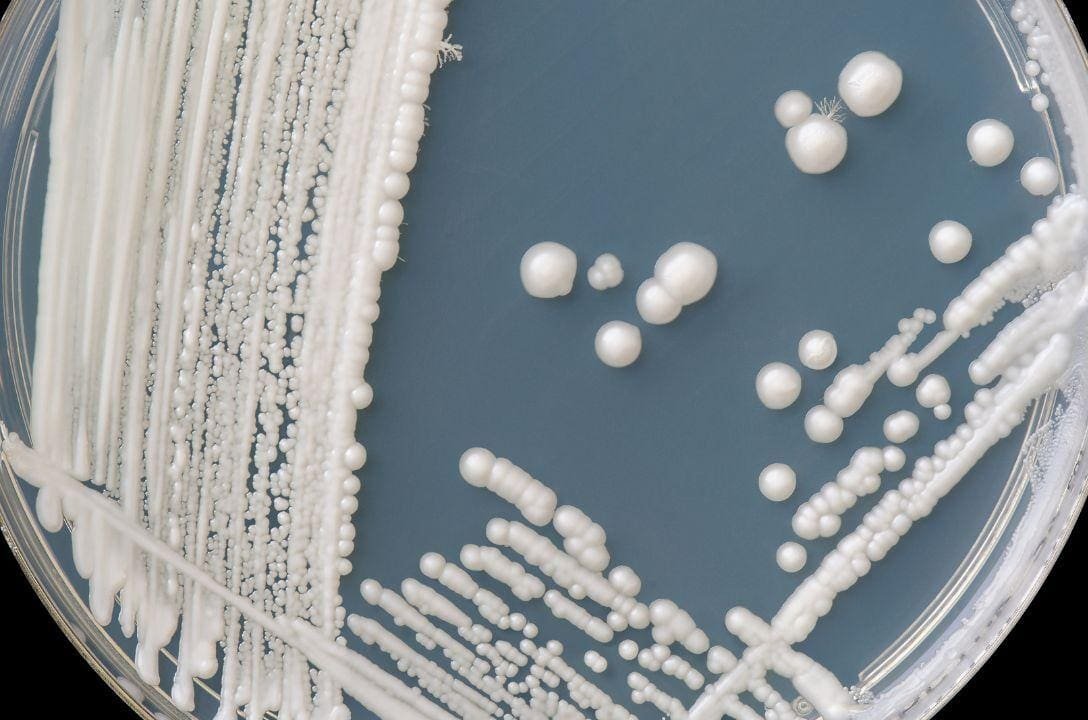

Você já ouviu falar de um inimigo invisível, quase indestrutível, que sobrevive por semanas em superfícies, desafia medicamentos e pode invadir órgãos como o cérebro, pulmões e ossos? Esse inimigo existe e tem nome: Candida auris, um superfungo que a Organização Mundial da Saúde (OMS) colocou na lista das maiores ameaças à saúde global.
O que é a Candida auris e por que ela preocupa tanto?
A Candida auris é uma espécie de levedura descoberta em 2009 no Japão, mas que, desde então, se espalhou rapidamente por diversos países. Ao contrário de fungos comuns, que raramente afetam pessoas saudáveis, o C. auris é altamente perigoso para pacientes hospitalizados, especialmente aqueles com o sistema imunológico enfraquecido.
Ele é capaz de infectar diferentes partes do corpo, incluindo corrente sanguínea, cérebro, medula espinhal, pulmões, ouvidos e ossos. Em casos graves, a taxa de mortalidade chega a 33% — ou seja, cerca de um em cada três infectados não sobrevive.
O que torna essa ameaça ainda mais assustadora é sua resistência. Muitas cepas são imunes aos medicamentos antifúngicos mais potentes, e o fungo ainda sobrevive mesmo após tentativas intensas de desinfecção.
Onde a Candida auris se esconde?
Uma das maiores armas do C. auris é sua capacidade de sobreviver no ambiente hospitalar por muito tempo. Ele pode ser encontrado em:
-
Superfícies como pias, maçanetas e bancadas
-
Equipamentos médicos como cateteres, sondas e estetoscópios
-
Roupas de cama e cortinas hospitalares
-
Radiadores, medidores de pressão e termômetros
Essa resistência ambiental significa que basta um pequeno descuido na higiene hospitalar para que o fungo se espalhe entre pacientes e profissionais de saúde.
Como a Candida auris se espalha?
O superfungo é transmitido principalmente por contato direto com superfícies ou equipamentos contaminados, além do contato com pessoas colonizadas.
O mais preocupante é que alguém pode carregar o fungo na pele sem apresentar sintomas por meses ou até anos, atuando como transmissor silencioso.
Por que é tão difícil de tratar?
O C. auris desenvolve resistência antifúngica rapidamente, tornando-se imune a medicamentos que antes funcionavam. Existem casos registrados em que o fungo não respondeu a nenhum dos três principais tipos de antifúngicos disponíveis na medicina moderna.
Essa resistência é resultado de mutações genéticas e também do uso indiscriminado de medicamentos antifúngicos e antibióticos, que favorecem o surgimento de microrganismos cada vez mais resistentes.
Quem corre mais risco?
O C. auris raramente infecta pessoas saudáveis. O perigo é maior para:
-
Pacientes internados por longos períodos
-
Pessoas em Unidades de Terapia Intensiva (UTIs)
-
Pacientes que receberam tratamento médico em países com surtos ativos
-
Indivíduos com imunidade comprometida
-
Pessoas com dispositivos médicos invasivos (como cateteres e sondas)
Como prevenir uma infecção por Candida auris?
Segundo autoridades de saúde como a OMS e a Agência de Segurança de Saúde do Reino Unido, algumas medidas essenciais são:
-
Lavar as mãos com água e sabão ou higienizar com álcool 70% regularmente
-
Usar equipamentos hospitalares esterilizados e de uso único sempre que possível
-
Monitorar pacientes que vieram de hospitais em regiões com surtos
-
Reduzir o uso de antibióticos e antifúngicos sem necessidade
-
Garantir limpeza rigorosa e frequente das superfícies hospitalares com desinfetantes específicos eficazes contra fungos
Curiosidades assustadoras sobre a Candida auris
-
Mistério da origem: cientistas ainda não sabem exatamente como a Candida auris surgiu, mas há teorias que relacionam seu aparecimento ao aquecimento global, que teria forçado fungos ambientais a se adaptarem a temperaturas próximas às do corpo humano.
-
Alerta mundial: já foram detectados casos nos cinco continentes, e surtos continuam sendo registrados em hospitais de países como EUA, Espanha, Índia, Reino Unido e Brasil.
-
Transmissão silenciosa: pacientes colonizados, mas sem sintomas, podem espalhar o fungo por meses sem saber.
-
Alta persistência: estudos mostram que o C. auris pode sobreviver em superfícies hospitalares por mais de 30 dias.
A Candida auris é o lembrete de que, no mundo microscópico, os inimigos mais perigosos não são sempre os mais visíveis. E, quando se trata de saúde global, a prevenção e a vigilância são as armas mais poderosas que temos.